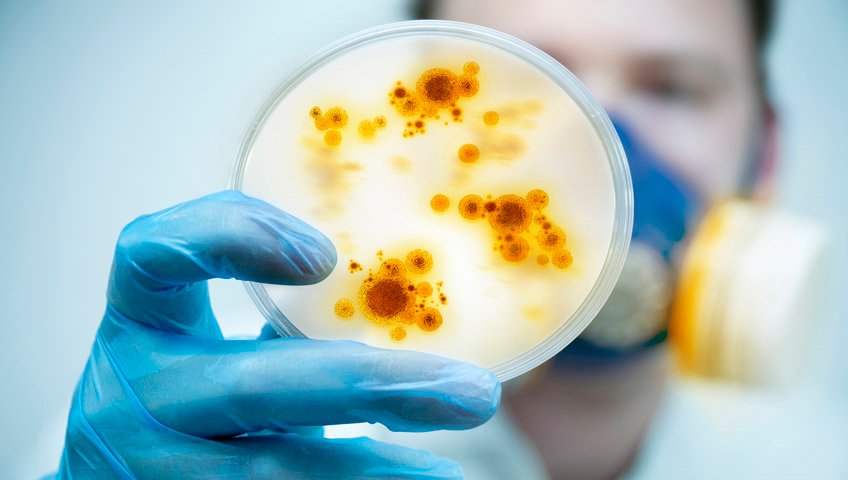
bebedouros não higienizados transmitem doenças

Qual a diferença entre filtro e purificador de água?
Nossa saúde está fortemente ligada à qualidade da água que bebemos. Por ser um elemento essencial ao funcionamento de nosso organismo, é fundamental que a água esteja sempre livre de micro-organismos nocivos à nossa saúde. Para isso, existem no mercado produtos que garantem uma bebida bem mais saudável: o purificador de água e o filtro de água.